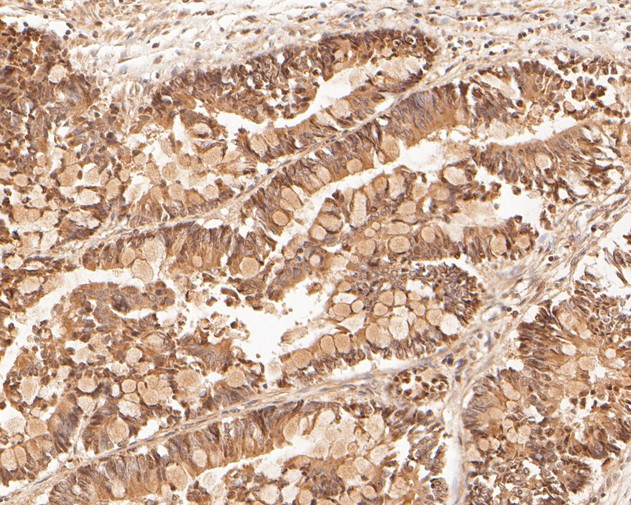
LSS Antibody in Immunohistochemistry (Paraffin) (IHC (P))

Search
Huabio
LSS Polyclonal Antibody
{{$productOrderCtrl.translations['antibody.pdp.commerceCard.promotion.promotions']}}
{{$productOrderCtrl.translations['antibody.pdp.commerceCard.promotion.viewpromo']}}
{{$productOrderCtrl.translations['antibody.pdp.commerceCard.promotion.promocode']}}: {{promo.promoCode}} {{promo.promoTitle}} {{promo.promoDescription}}. {{$productOrderCtrl.translations['antibody.pdp.commerceCard.promotion.learnmore']}}
图: 1 / 5
LSS Antibody (HA500011) in IHC (P)





产品信息
HA500011
种属反应
宿主/亚型
分类
类型
抗原
偶联物
形式
浓度
规格
纯化类型
保存液
内含物
保存条件
运输条件
靶标信息
The protein encoded by this gene catalyzes the conversion of (S)-2, 3 oxidosqualene to lanosterol. The encoded protein is a member of the terpene cyclase/mutase family and catalyzes the first step in the biosynthesis of cholesterol, steroid hormones, and vitamin D. Alternative splicing results in multiple transcript variants encoding different isoforms.
仅用于科研。不用于诊断过程。未经明确授权不得转售。
篇参考文献 (0)
生物信息学
蛋白别名: 2,3-epoxysqualene--lanosterol cyclase; 2,3-epoxysqualene-lanosterol cyclase; epididymis secretory sperm binding protein; hOSC; Lanosterol synthase; lanosterol synthase (2,3-oxidosqualene-lanosterol cyclase); OSC; Oxidosqualene--lanosterol cyclase; unnamed protein product
基因别名: 2810025N20Rik; APMR4; CTRCT44; D10Ertd116e; HYPT14; LSS; OSC
UniProt ID: (Human) P48449, (Mouse) Q8BLN5
Entrez Gene ID: (Human) 4047, (Mouse) 16987